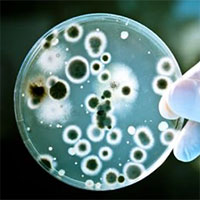
Trí tuệ nhân tạo tìm ra thuốc kháng sinh kỳ diệu chưa từng có

Đời sống
Đời sống
Các thông tin mới nhất về y học sức khỏe như y học sức khỏe ăn uống, sức khỏe điều trị, sức khỏe thực phẩm, sức khỏe dinh dưỡng, sức khỏe uống rượu, sức khỏe thuốc, sức khỏe và đời sống, sức khỏe sinh sản

Biến gạo thành đồ nhựa an toàn mang lại hy vọng cho Fukushima sau thảm hoạ hạt nhân
Jinichi Abe biết rằng gạo ông trồng tại thị trấn Namie, tỉnh Fukushima (Nhật Bản) vẫn sẽ có người mua ổn định, mặc dù nơi đây đang cố gắng hồi phục sau thảm họa kép động đất và sóng thần năm 2011.
Đăng ngày: 10/03/2023

Vệt mây kỳ lạ lóe sáng trong đêm "trăng giun"
Hình ảnh một đám mây mỏng "lạ thường" được chiếu sáng bởi trăng tròn tháng 3 - thường được gọi là "trăng giun" - đang thu hút sự chú ý trên mạng xã hội.
Đăng ngày: 10/03/2023

Con người đã xả hơn 170.000 tỷ hạt vi nhựa vào đại dương
Lượng rác thải nhựa đổ ra các đại dương trên thế giới tăng mạnh chưa từng thấy kể từ năm 2005, có thể tăng gấp gần 3 lần vào năm 2040 nếu thế giới không hành động quyết liệt.
Đăng ngày: 10/03/2023

Phát hiện hang động băng lớn nhất Tây Tạng
Trung Quốc hôm 7/3 công bố phát hiện một hang động băng khổng lồ gần "hồ ba màu" ở khu tự trị Tây Tạng, phía tây nam nước này.
Đăng ngày: 10/03/2023

Hội chứng West là gì?
Đừng bỏ qua dấu hiệu nhận biết nếu bạn không muốn con bị bệnh nặng trước khi phát hiện.
Đăng ngày: 09/03/2023

Những lầm tưởng về viên nén cà phê
Khi nhắc đến việc pha cà phê, viên nén được cho là không thân thiện với môi trường vì chúng thường khó tái chế, nhưng đây không phải thủ phạm lớn nhất phát thải khí nhà kính.
Đăng ngày: 09/03/2023

Kỳ lạ cơn bão sống dai nhất thế giới, tung hoành cả tháng chưa dứt
Freddy vừa lập kỷ lục mới, trở thành cơn bão nhiệt đới tồn tại lâu nhất thế giới - kể từ khi hình thành ở ngoài khơi bờ biển Úc vào đầu tháng 2 cho đến nay.
Đăng ngày: 09/03/2023

Mẹo ăn uống hạn chế triệu chứng khó chịu, người bị trào ngược dạ dày - thực quản nên biết
Chế độ ăn uống đóng vai trò quan trọng việc kiểm soát các triệu chứng của trào ngược axit và là biện pháp đầu tiên được khuyên áp dụng cho những người bị trào ngược dạ dày - thực quản.
Đăng ngày: 08/03/2023

Chiếc áo giúp người dùng che mắt camera an ninh
Chiếc áo này được gắn đèn LED hồng ngoại công suất cao, giúp người mặc không bị nhận ra bởi camera ban đêm.
Đăng ngày: 08/03/2023

Thịt gà sống để được bao lâu trong tủ lạnh?
Tích trữ thực phẩm trong tủ lạnh là một thói quen rất phổ biến, nhưng việc tích trữ quá nhiều thực phẩm có thể gây hại cho sức khỏe nếu không lưu trữ và sử dụng đúng cách.
Đăng ngày: 07/03/2023

Những loại thực phẩm phổ biến gây béo bụng
Để giảm tích tụ mỡ bụng, bạn nên tránh xa các thực phẩm dưới đây.
Đăng ngày: 06/03/2023

Trung Quốc ghi nhận ca nhiễm H5N1 nhánh 2.3.4.4b
Theo The Telegraph, một người phụ nữ 53 tuổi ở Trung Quốc gần đây đã phải nhập viện vì chủng cúm gia cầm - loại cúm đang lây nhiễm sang các loài động vật có vú trên khắp thế giới.
Đăng ngày: 06/03/2023
Trí tuệ nhân tạo tìm ra thuốc kháng sinh kỳ diệu chưa từng có
Trí tuệ nhân tạo (AI) đã giúp các nhà khoa học Mỹ tìm ra một loại hợp chất kỳ diệu là halicin vốn chưa từng thấy trước đây, có khả năng tiêu diệt nhiều loại vi khuẩn kháng thuốc.
Đăng ngày: 06/03/2023

Gạch in 3D từ vỏ trứng góp phần giải quyết vấn đề ô nhiễm và lãng phí thực phẩm
Gạch in 3D từ vỏ trứng do công ty Manufactura sản xuất có thể góp phần giải quyết vấn đề ô nhiễm môi trường và lãng phí thực phẩm.
Đăng ngày: 06/03/2023

Thiết bị mới có thể phát hiện tế bào ung thư mà không cần sinh thiết
Các nhà nghiên cứu ở Australia đã phát triển một thiết bị mới có thể phát hiện các tế bào ung thư từ mẫu máu, giúp bệnh nhân tránh phải phẫu thuật sinh thiết xâm lấn.
Đăng ngày: 06/03/2023

Chất hóa học từ giấy vệ sinh có thể gây ung thư
Mới đây, các nhà nghiên cứu phát hiện giấy vệ sinh có những hợp chất có khả năng gây ung thư. Những hóa chất này trước đây cũng được tìm thấy trong mỹ phẩm, quần áo, đồ trẻ em.
Đăng ngày: 06/03/2023
Tiêu điểm



